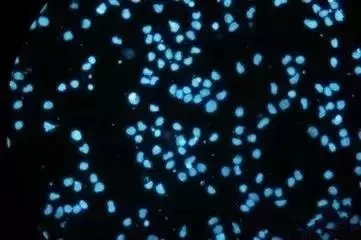
生物降解塑料檢測標準是什么樣

項目簡介
醫療器械檢測是確保產品安全、有效與合規的關鍵環節,涵蓋性能驗證、材料安全及生物相容性測試,旨在預防潛在風險,保護患者健康,推動行業持續發展。
服務項目
醫用敷料類、醫用輸注器具及醫用導管類、藥械組合醫療器械、醫美產品
服務優勢
資質完備:已獲得國家CMA、省級CMA及CNAS資質,檢測結果權威可靠。
項目全面:提供理化/微生物檢測、生物相容性研究(依據GB/T 16886/ISO 10993)及臨床前功能性評價的一站式服務。
專業團隊:擁有經驗豐富的檢測隊伍,精通各類醫療器械標準與流程,確保高效精準服務。
風險控制:通過體外/體內實驗綜合評價產品安全性,助力產品合規上市,提升市場競爭力。




立即咨詢
留言咨詢